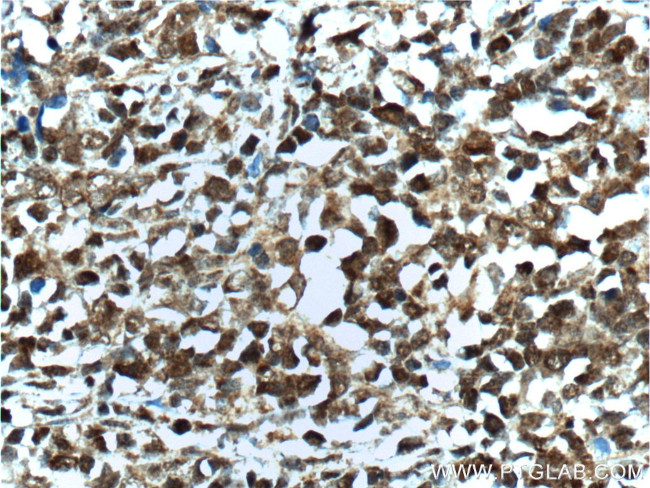
BCL6 Antibody in Immunohistochemistry (Paraffin) (IHC (P))
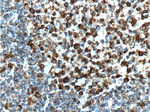
BCL6 Antibody in Immunohistochemistry (Paraffin) (IHC (P))

Search
Proteintech
BCL6 Polyclonal Antibody
{{$productOrderCtrl.translations['antibody.pdp.commerceCard.promotion.promotions']}}
{{$productOrderCtrl.translations['antibody.pdp.commerceCard.promotion.viewpromo']}}
{{$productOrderCtrl.translations['antibody.pdp.commerceCard.promotion.promocode']}}: {{promo.promoCode}} {{promo.promoTitle}} {{promo.promoDescription}}. {{$productOrderCtrl.translations['antibody.pdp.commerceCard.promotion.learnmore']}}
产品信息
21187-1-AP
种属反应
已发表种属
宿主/亚型
分类
类型
抗原
偶联物
形式
浓度
规格
纯化类型
保存液
内含物
保存条件
运输条件
产品详细信息
Immunogen sequence: SLYSGLSTP PASYSMYSHL PVSSLLFSDE EFRDVRMPVA NPFPKERALP CDSARPVPGE YSRPTLEVSP NVCHSNIYSP KETIPEEARS DMHYSVAEGL KPAAPSARNA PYFPCDKASK EEERPSSEDE IALHFEPPNA PLNRKGLVSP QSPQKSDCQP NSPTESCSSK NACILQASGS PPAKSPTDPK ACNWKKYKFI VLNSLNQNAK PEGPEQAELG RLSPRAYTAP PACQPPMEPE NLDLQSPTKL SASGEDSTIP QASRLNNIVN RSMTGSPRSS SESHSPLYMH PPKCTSCGSQ SPQHAEMCLH TAGPTFPEEM GETQSEYSDS SCENGAFFCN ECDCRFSEEA S (183-532 aa encoded by BC150184)
靶标信息
Bcl-6 proto-oncogene product (a Kruppel-type zinc-finger protein) is mainly expressed in normal germinal center B cells and related lymphomas. Bcl-6 is involved in chromosome rearrangements at 3q27 in non-Hodgkin's lymphomas and Bcl-6 rearrangements have been detected in 33%-45% of diffuse large B cell lymphomas. Bcl-6 has been detected immunohistochemically in follicular lymphomas, diffuse large B cell lymphomas, Burkitt's lymphomas and in nodular, lymphocyte predominant Hodgkin's disease.
仅用于科研。不用于诊断过程。未经明确授权不得转售。
生物信息学
蛋白别名: B cell CLL/lymphoma 6; B-cell lymphoma 5 protein; B-cell lymphoma 5 protein (BCL5); B-cell lymphoma 6 protein; B-cell lymphoma 6 protein transcript; BCL-5; BCL-6; cys his2 zinc finger transcription factor; cys-his2 zinc finger transcription factor; LAZ-3 protein; Lymphoma Associated Zinc Finger Gene On Chromosome 3 (LAZ3); lymphoma-associated zinc finger gene on chromosome 3; Protein LAZ-3; transcriptional repressor; B-cell CLL/lymphoma 6 spliced short isoform; transcriptional repressor; zinc finger protein 51; unnamed protein product; Zinc finger and BTB domain-containing protein 27; Zinc finger and BTB domain-containing protein 27 (ZBTB27); Zinc finger protein 51; Zinc Finger Protein 51 (ZNF51); zinc finger transcription factor BCL6S
基因别名: BCL5; BCL6; BCL6A; LAZ3; ZBTB27; ZNF51
UniProt ID: (Human) P41182
Entrez Gene ID: (Human) 604